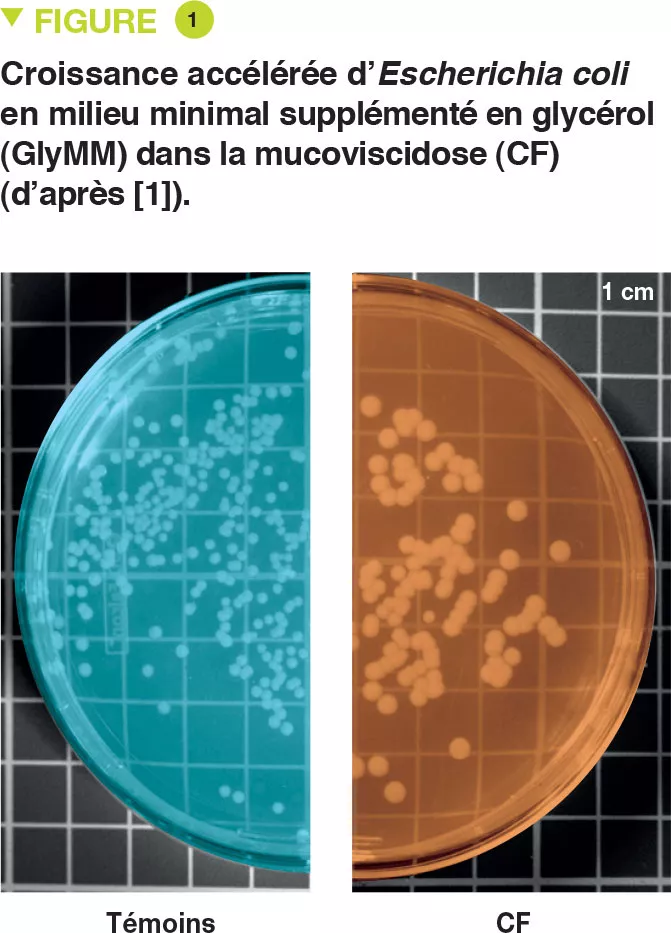

Adaptation des Escherichia coli commensales dans le tractus intestinal de jeunes enfants atteints de mucoviscidose
Article commenté - rubrique enfant
Par le Pr. Emmanuel Mas
Gastro-entérologie et nutrition, Hôpital des Enfants, Toulouse, France
en_sources_title
en_sources_text_start en_sources_text_end
Chapitres

A propos de cet article
Commentaire de l’article original de Matamouros et al. (PNAS 2018)
Le microbiote intestinal humain mature se met en place au cours des premières années de la vie, or des altérations des microbiomes intestinaux ont été associées à plusieurs problèmes de santé chez l’homme. Escherichia coli représente généralement moins de 1 % du microbiome intestinal humain, alors que dans la mucoviscidose, une relative abondance (> 50 %) est fréquente et corrélée à l’inflammation intestinale et à la stéatorrhée. Malgré la prolifération d’E. coli et autres protéobactéries dans des conditions impliquant une inflammation chronique du tractus gastro-intestinal, on sait peu de chose sur l’adaptation de caractéristiques spécifiques liées à l’expansion clonale du microbiote.
Cette étude met en évidence qu’E. coli isolée à partir d’échantillons de selles de jeunes enfants ayant la mucoviscidose a adapté sa croissance à la présence de glycérol, un composant majeur des graisses. Les isolats d’E. coli issus de différents patients atteints de mucoviscidose révèlent un taux de croissance accru en présence de glycérol par rapport aux E. coli issues de sujets sains, tandis que des souches d’E. coli non associées à la mucoviscidose ont acquis de manière indépendante cette caractéristique de croissance. En outre, ces isolats des enfants ayant la mucoviscidose et des contrôles montrent une expression génique différentielle lorsqu’ils sont cultivés dans des milieux minimaux dont la seule source de carbone est le glycérol. Alors que les isolats des enfants ayant la mucoviscidose présentent un profil transcriptionnel favorisant la croissance, ceux des contrôles impliquent l’induction de stress et d’une phase stationnaire, ce qui peut entraîner des taux de croissance plus lents. Ces résultats mettent en évidence l’existence d’une sélection de caractéristiques uniques au sein du microbiome des personnes souffrant de mucoviscidose, qui pourrait contribuer au pronostic individuel de la maladie [1].
Que sait-on déjà à ce sujet ?
La principale atteinte digestive de la mucoviscidose est l’insuffisance pancréatique exocrine. Elle est présente dans 85 % des cas et elle nécessite une supplémentation en extraits pancréatiques. Malgré cette supplémentation, une malabsorption des graisses peut persister. La proportion d’E. coli dans le microbiome intestinal humain est en général inférieure à 1 % mais elle peut atteindre jusqu’à 70-80 % chez les sujets atteints de mucoviscidose. Il existe une expansion clonale chez un patient mais les souches sont différentes entre les patients, ce qui suggère une adaptation d’E. coli à son environnement. Certaines souches d’E. coli sont impliquées dans l’inflammation intestinale et dans le cancer colorectal. Dans la mucoviscidose, on peut retrouver une inflammation digestive, une dysbiose, voire un risque augmenté de cancer colorectal selon des données récentes.
Les auteurs ont émis l’hypothèse qu’a lieu, dans la mucoviscidose, une sélection de souches d’E. coli, capables de survivre dans un milieu intestinal contenant un excès de graisses et un mucus anormal.
Quels sont les principaux résultats apportés par cette étude ?
E. coli a été isolée de selles de 6 jeunes enfants atteints de mucoviscidose et de 2 témoins. Les auteurs ont évalué la croissance de ces bactéries dans un milieu minimal dont la seule source de carbone était une supplémentation en glucose (GluMM) ou glycérol (GlyMM). La croissance d’E. coli était plus rapide dans des plaques GlyMM pour des souches isolées d’enfants ayant la mucoviscidose que pour celles isolées de témoins (Figure 1). Ces différences n’étaient pas observées en conditions anaérobies. Le milieu intestinal étant essentiellement anaérobie, il est possible que l’oxygène joue un rôle important. À proximité de l’épithélium, il existe un gradient minimal d’oxygène.
L’analyse génétique a montré que les souches d’E. coli étaient distinctes. En outre, les 8 isolats avaient plus de 11 000 SNP (single nucleotide polymorphisms) présents chez un ou plusieurs enfants ayant la mucoviscidose mais absents des témoins. L’analyse transcriptomique (RNA-seq), en milieu GluMM ou GlyMM, a été réalisée sur des isolats de 2 enfants souffrant de mucoviscidose et de 2 témoins ; ces isolats avaient été sélectionnés en raison de leur croissance en milieu GlyMM et de leur positionnement sur l’arbre phylogénétique. Parmi les gènes exprimés différemment, 213 gènes étaient surexprimés (absorption et métabolisme du glycérol), et 6 sous-exprimés (transport cellulaire du glucose) en milieu GlyMM de manière identique chez les enfants ayant la mucoviscidose et les témoins. En milieu GluMM, seuls 20 gènes étaient exprimés différemment dans la mucoviscidose et chez les témoins, tandis que 405 l’étaient en milieu GlyMM (377 gènes non induits dans la mucoviscidose) (Figure 2). Ces gènes sous-exprimés dans la mucoviscidose en milieu GlyMM codaient pour des protéines impliquées dans le stress, la résistance acide et la formation de biofilm. Les gènes surexprimés dans la mucoviscidose ou sous-exprimés chez les témoins codaient pour des protéines impliquées dans des mécanismes de croissance. Dans la mucoviscidose, l’augmentation de croissance en milieu GlyMM ne serait pas liée à une reprogrammation métabolique mais à une perte de l’inhibition de croissance et de réponse au stress.

Points clés
-
Il existe une dysbiose au niveau intestinal dans la mucoviscidose. On retrouve notamment une augmentation très importante d’E. coli.
-
En raison de la malabsorption des graisses, il existe une augmentation du glycérol au niveau intestinal. Ces souches d’E. coli sélectionnées dans la mucoviscidose se sont adaptées à ces conditions avec des gènes exprimés différemment et une perte de l’inhibition de croissance.
Quelles sont les conséquences en pratique ?
Cette étude permet de comprendre des mécanismes impliqués dans la dysbiose associée à la mucoviscidose pour ce qui concerne E. coli. Afin de corriger cette dysbiose et de limiter, au moins en partie, l’inflammation intestinale, il est important d’optimiser l’absorption intestinale des graisses pour réduire la quantité de glycérol. Une amélioration de la barrière intestinale, notamment du mucus dans cette maladie, pourrait aussi réduire la disponibilité en oxygène nécessaire à la croissance de ces souches d’E. coli.
Conclusion
Dans la mucoviscidose, la quantité importante de glycérol présent dans l’intestin en raison de la malabsorption des graisses entraîne une adaptation des E. coli avec une prolifération clonale. La compréhension de ces mécanismes pourrait permettre de développer de nouvelles approches thérapeutiques et d’améliorer la prise en charge des malades.